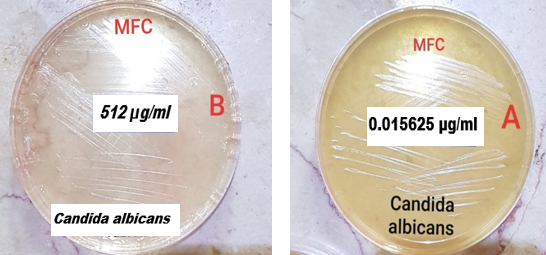

Investigation
of the effect of watery and alcoholic extract of Arnebia euchroma on the
growth of Candida species isolated from patients with COVID-19 associated
oral candidiasis using microdilution method
Zahra Rafat 1, Davoud Roostaei 2*,
Kourosh Delpasand 3*, Farnaz
Farzin 4
1 Department
of Medical Parasitology and Mycology, School of Medicine, Guilan University of
Medical Sciences, Rasht, Iran
2 Department
of Pharmacology, School of Medicine, Guilan University of Medical Sciences,
Rasht, Iran
3 Department
of Medical Ethics, School of Medicine, Guilan University of Medical Sciences,
Rasht, Iran
4 Student
research committee, Anzali International Medical Campus, Guilan University of
Medical Sciences, Rasht, Iran
Corresponding Authors: Davoud
Roostaei * Email: droostaei@gmail.com
Kourosh
Delpasand * Email: kd388@yahoo.com
Abstract
Introduction: Conventional antifungals used to treat fungal infections are no longer
as effective, leading to increased mortality. On the other hand, there is an
emergence of multidrug-resistant (MDR) fungal strains and for this reason,
finding new treatments or substances that have an antifungal effect is
noticeable. Therefore, this study aimed to determine the antifungal effects of
extracts of Arnebia euchroma on the growth of Candida species
isolated from patients with COVID-19-associated oral candidiasis.
Materials and Methods: Conventional antifungals used to treat fungal infections are no longer
as effective, leading to increased mortality. On the other hand, there is an
emergence of multidrug-resistant (MDR) fungal strains and for this reason,
finding new treatments or substances that have an antifungal effect is
noticeable. Therefore, this study aimed to determine the antifungal effects of
extracts of Arnebia euchroma on the growth of Candida species isolated
from patients with COVID-19-associated oral candidiasis.
Results: The results of the present study showed that all the investigated
isolates were sensitive to watery and alcoholic extracts of Arnebia euchroma.
The MIC and MFC of Arnebia euchroma watery extract for Candida
albicans were 512 µg/mL and for Candida glabrata were 1024 µg/m, as
well as the MIC and MFC of this extract for Candida tropicalis, Candida
parapsilosis, and Candida krusei were 2048 µg/mL. Whereas the MIC
and MFC of the Arnebia euchroma alcoholic extract for Candida albicans
were 0.015625 µg/mL and for Candida glabrata were 256 µg/mL, also the
MIC and MFC of this extract for Candida tropicalis and Candida
parapsilosis were 512 µg/mL and for Candida krusei were 1024 µg/mL.
Conclusion: All the studied Candida isolates were sensitive to both types
of Arnebia euchroma root extract, and the alcoholic extract, compared
with the watery extract, inhibited the growth of the tested Candida
isolates at a lower concentration
Keywords: COVID-19, Candida albicans, Candida glabrata, Candida
tropicalis, Candida parapsilosis, Candida krusei
Introduction
The
immune dysregulation triggered by severe acute respiratory syndrome coronavirus
2 (SARS‐CoV‐2) infection has been hypothesized as a causal pathway for the
increasingly reported oral manifestations associated with coronavirus diseases
(COVID‐19), especially the ones of fungal origin. Oral candidiasis is a common
opportunistic fungal infection of the oral cavity caused by an overgrowth
of Candida species (1,2).
In healthy individuals, Candida exists harmlessly in mucus
membranes such as the ears, eyes, gastrointestinal tract, mouth, nose,
reproductive organs, sinuses, skin, stool, and vagina, but in some patients, it
can overgrow and cause symptoms (3). Oral candidiasis causes creamy white lesions,
usually on the tongue or inner cheeks. Sometimes it may spread to the roof of
the mouth, the gums or tonsils, or the back of the throat (1).
The
most common cause of COVID-19-associated oral candidiasis includes Candida albicans,
Candida glabrata, Candida krusei, Candida parapsilosis,
and Candida tropicalis (4,5). Candida albicans are recovered
from 60% of dentate patients' mouths over the age of 60 years.
On
the other hand, antifungal resistance represents a major clinical challenge to
clinicians responsible for treating oral candidiasis due to the limited arsenal
of available antifungal agents. In addition, current drugs may be limited by drug–drug
interactions and serious adverse effects/toxicities that prevent their
prolonged use or dosage escalation (6). Changes in Candida spp.
distribution may impact treatment recommendations due to differences in
susceptibility to antifungal agents among different spp. Antifungal agents
available for the treatment of oral candidiasis are restricted to polyenes, azoles,
and the most recent echinocandin class. The emergence of multidrug-resistant
strains that are insensitive to several classes of antifungals is a major
concern worldwide (6,7). For these reasons, finding new treatments or substances that have
an antifungal effect is noticeable.
One
of the most common herbal drugs that are used in traditional medication is
Abukhals (Arnebia euchroma) from the family
of Boraginaceae. This plant is herbaceous, with sharp silver pubes and the
flower is cluster shaped with stretched and alternate leaves (8-12). One of the
most common habitats of this plant is Iran, especially Rasht. The
root of this plant was used in reducing the swellings and had anticancer
activity. It caused mild constipation and was used in nourishing the liver,
kidneys, and spleen. New studies have shown that its extracts contain shikonin
which is used in the treatment of burns and dermatitis, proliferation of skin’s
stem cells, improving arthritis, and inhabitation of inflammation by its
antibacterial and antifungal effects (8-12).
In various studies conducted around the world, the antiviral and
antibacterial properties of Arnebia euchroma have been
proven (13,14), but so far there is no comprehensive study evaluating the
antifungal effect of this plant in the treatment of oral candidiasis. The
economic value of Arnebia euchroma as an herbal medicine and its
use in cosmetics, food, and personal care products, and the lack of knowledge
about antifungal susceptibility profiles of fungal elements causing oral
candidiasis against Arnebia euchroma among Iranian patients prompted us
to conduct a comprehensive study to fill this gap. It is important to have
antifungal agents that will treat fungal infections without leading to
increased resistance, though the use of azoles and echinocandin antifungal
drugs against Candida species has seen this happen. As changes
are seen in the resistance of fungi to antifungal drugs, in the present study
we aimed to assess the antifungal effects of extracts of Arnebia euchroma on
the growth of fungal agents isolated from COVID-19-associated oral candidiasis in Iran as a new antifungal agent.
Materials and Methods
The roots of Arnebia euchroma were collected from the local
areas of Rasht, north of Iran. It was authenticated from the proper source and
a voucher specimen No: 01 was deposited in the Department of Pharmacognosy,
Guilan University of Medical Sciences, Rasht, Iran.
Preparation
of Plant Extracts
Collected
roots were dried on mats in the shade and at room temperature, spread into thin
layers that were not mixed over the 10-day drying period. The extraction
process was conducted using 96% ethanol (for alcoholic extracts) and distilled
water (for watery extracts). For preparing alcoholic extract a powdered leaf
(100 g) was added to 500 mL of ethanol and for preparing watery extract 100 g
of the powder was added to 500 mL of distilled water. The extraction was carried out for 72 hours
at room temperature with mild shaking. The extracts were filtered and
concentrated at 37° C for 48 hours (15,16).
Fungal
species
The
antifungal activity was carried out against C. albicans, C. tropicalis, C. krusei, C. glabrata, and C. parapsilosis clinical isolates. All the mentioned isolates were
previously collected from clinical specimens of patients with COVID-19-associated oral candidiasis hospitalized in Razi Hospital in Rasht City, Guilan, Iran (ethical
code: IR.TUMS.SPH.REC.1400.030) and were
recognized previously to the species level through sequencing of the internal
transcribed spacer (ITS1-5.8s-ITS2) gene. Also, the standard strains of Candida
albicans (ATCC 10231), Candida glabrata (ATCC 48465), Candida
krusei (ATCC 2159), Candida tropicalis (ATCC 750), and Candida
parapsilosis (ATCC 22019), which were obtained in lyophilized from the
microbial collection of Iranian Biological Resource Center (IBRC, No. 80, West
Hoveizeh St, North Sohrevardi Ave, Tehran, Iran) were included in the study.
Antifungal
Activity Assessment
In
vitro,
antifungal susceptibility testing was performed against isolated strains
according to the protocols described by the Clinical and Laboratory Standards
Institute (CLSI) guidelines, document M27-A3 for yeasts (17). Briefly, by
employing 24 hours cultures of yeast isolates on sabouraud dextrose agar (SDA;
Difco) homogeneous yeast conidial suspensions were spectrophotometrically
measured at the 530 nm wavelength and a percent transmission within the range
of 75- 77%. The final inoculum suspension was adjusted to 105
conidia/mL in RPMI 1640 medium (GIBCO, UK) buffered at pH 7.0 with 0.165 M
morpholino propane sulfonic acid (MOPS, Sigma-Aldrich, St. Louis, MO, USA). For
the determination of antimicrobial activities against all of the studied
microorganisms, the concentration of each plant extract was diluted two-fold
from 4096 µg/mL to 0.00390625 µg/mL. After adding 100 µl of the inoculum
suspension the microdilution plates were incubated at 35°C for 48 h; the plates
were read visually according to the recommendations proposed by the CLSI M27-A3
document. The microdilution plates were inoculated with 100 µl of the diluted
conidial inoculum suspension and incubated at 35 °C for 48 h. The plates were
read visually according to the recommendations proposed by the CLSI M27-A3
document. Reference strains of C. parapsilosis (ATCC 22019) and C.
krusei (ATCC 6258) were used for quality control purposes. MIC was
interpreted as the lowest concentration of the sample, which showed clear fluid
without the development of turbidity.
Ethics
Statement
The
study was approved by the Research Ethics Committee of Guilan University of
Medical Sciences (the number of ethics committee protocol: IR.GUMS.REC.1401.526).
Statistical
analysis
MIC
values were calculated for clinical and standard samples and the strains were
compared. For statistical analysis, a Chi-square test of homogeneity was
performed at a significance level of 5 % (18).
Results
In
the present study, the minimum inhibitory concentration
(MIC) and minimum fungicidal concentration (MFC) of watery
and alcoholic extracts of Arnebia euchroma on the growth
of Candida species isolated from
patients with COVID-19 associated oral candidiasis (C. albicans, C. tropicalis,
C. parapsilosis, C. krusei, and C. glabrata) were evaluated
using broth microdilution method.
Table
1 presents the MIC of the watery and alcoholic extracts
of Arnebia euchroma against tested Candida. The results
demonstrate that all the mentioned Candida species against the
watery and alcoholic extracts of
Arnebia euchroma showed sensitivity.
The
MIC and MFC of Arnebia euchroma
watery extract for Candida albicans were ![]() µg/mL and for Candida
glabrata were
µg/mL and for Candida
glabrata were ![]() µg/mL, as well as the MIC and MFC of this extract for Candida tropicalis,
Candida parapsilosis, and Candida krusei were
µg/mL, as well as the MIC and MFC of this extract for Candida tropicalis,
Candida parapsilosis, and Candida krusei were ![]() µg/mL. Whereas the MIC and MFC of Arnebia euchroma alcoholic extract
for Candida albicans were
µg/mL. Whereas the MIC and MFC of Arnebia euchroma alcoholic extract
for Candida albicans were ![]() µg/mL and for Candida glabrata were
µg/mL and for Candida glabrata were ![]() µg/mL, also the MIC and MFC of this extract
for Candida tropicalis and Candida parapsilosis were
µg/mL, also the MIC and MFC of this extract
for Candida tropicalis and Candida parapsilosis were ![]() µg/mL and for Candida krusei were
µg/mL and for Candida krusei were ![]() µg/mL (Table 1, Figure 1).
µg/mL (Table 1, Figure 1).